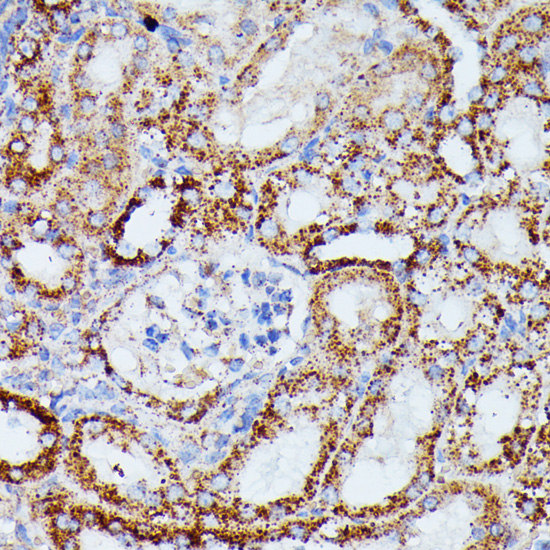
Immunohistochemistry - IDH3A Polyclonal Antibody

-
Product Name
IDH3A Polyclonal Antibody
- Documents
-
Description
Polyclonal antibody to IDH3A
-
Tested applications
WB, IHC
-
Species reactivity
Human, Mouse, Rat
-
Alternative names
IDH3A antibody; isocitrate dehydrogenase 3 (NAD(+)) alpha antibody
-
Isotype
Rabbit IgG
-
Preparation
Antigen: Recombinant fusion protein containing a sequence corresponding to amino acids 28-366 of human IDH3A (NP_005521.1).
-
Clonality
Polyclonal
-
Formulation
PBS with 0.02% sodium azide, 50% glycerol, pH7.3.
-
Storage instructions
Store at -20℃. Avoid freeze / thaw cycles.
-
Applications
WB 1:500 - 1:2000
IHC 1:50 - 1:200 -
Validations

Western blot - IDH3A Polyclonal Antibody
Western blot analysis of extracts of various cell lines, using IDH3A antibody at 1:1000 dilution.Secondary antibody: HRP Goat Anti-Rabbit IgG (H+L) at 1:10000 dilution.Lysates/proteins: 25ug per lane.Blocking buffer: 3% nonfat dry milk in TBST.Detection: ECL Basic Kit .Exposure time: 1s.

Immunohistochemistry - IDH3A Polyclonal Antibody
Immunohistochemistry of paraffin-embedded rat kidney using IDH3A antibody at dilution of 1:100 (40x lens).

Immunohistochemistry - IDH3A Polyclonal Antibody
Immunohistochemistry of paraffin-embedded human thyroid cancer using IDH3A antibody at dilution of 1:100 (40x lens).

Immunohistochemistry - IDH3A Polyclonal Antibody
Immunohistochemistry of paraffin-embedded human colon carcinoma using IDH3A antibody at dilution of 1:100 (40x lens).
Immunohistochemistry - IDH3A Polyclonal Antibody
Immunohistochemistry of paraffin-embedded mouse kidney using IDH3A antibody at dilution of 1:100 (40x lens).
-
Background
Catalytic subunit of the enzyme which catalyzes the decarboxylation of isocitrate (ICT) into alpha-ketoglutarate. The heterodimer composed of the alpha (IDH3A) and beta (IDH3B) subunits and the heterodimer composed of the alpha (IDH3A) and gamma (IDH3G) subunits, have considerable basal activity but the full activity of the heterotetramer (containing two subunits of IDH3A, one of IDH3B and one of IDH3G) requires the assembly and cooperative function of both heterodimers.
Related Products / Services
Please note: All products are "FOR RESEARCH USE ONLY AND ARE NOT INTENDED FOR DIAGNOSTIC OR THERAPEUTIC USE"
